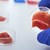
Учени отгледаха "бекон в епруветка"

Учени откриват все повече доказателства, че мечките не са месоядни
- Редактор: Петя Георгиева
- Коментари: 2

Хранителният режим с високо съдържание на протеини бавни ги убива, заяви професор Чарлз Робинс
Мечките не са котки или кучета и храненето им в зоопарковете вероятно съкращава живота им, е мнението на американски учени, цитирани от електронното издание Юрикалърт и БТА.
Проучване, публикувано в "Сайънтифик рипортс" и посветено на диетата на големите панди и на бърнестите мечки дава още доказателства, че тези животни са всеядни като хората и се нуждаят от много по-малко протеини в сравнение с тези, които обикновено получават с храната в зоологическите градини.
"Мечките не са месоядни животни в най-тесния смисъл като котка, чийто хранителен режим е с високо съдържание на протеини", обяснява водещият автор Чарлз Робинс, професор във Вашингтонския университет. "В зоологическите градини винаги, независимо дали става въпрос за полярни, кафяви или бърнести мечки, препоръката е да бъдат хранени сякаш са месоядни животни и имат потребност от високо съдържание на протеини. Когато правите това, всъщност, бавно ги убивате", предупреждава специалистът.
При отделни експерименти учените предоставят на големи панди и бърнести мечки в зоологически градини в САЩ възможност за неограничено количество храна от различни видове, като целта е да видят предпочитанията на животните. Те водят дневник за избора им.
В сътрудничество с изследователи от Тексаския университет Ей енд Ем и зоопарка в Мемфис специалистите тестват вкуса на двойка големи панди, за да се установи предпочитаният от тях бамбук.
Оказва се, че пухкавите животни предпочитат богатите на въглехидрати стъбла вместо съдържащите повече протеини листа. В определени моменти пандите консумират почти изцяло култивирано растение, например през 98 процента от времето през месец март. Изследователите анализират и данни от пет китайски зоопарка с големи панди, които успешно са се размножили и чийто хранителен режим е с високо съдържание на въглехидрати и ниско ниво на протеини.
В няколко проучвания на хранителните навици на шест бърнести мечки в зоологически градини в Кливланд, Литъл Рок и Сан Диего са представени в неограничени количества авокадо, печени сладки картофи и ябълки. Те избират почти изцяло богатото на мазнини авокадо, като консумират приблизително 88 процента от него към 12 процента сладки картофи и пренебрегват всички ябълки. Това показва, че бърнестите мечки предпочитат продукти с високо съдържание на мазнини и малко въглехидрати, а подобна диета в дивата природа включва термити и мравки, също техните яйца и ларви.
Предпочитаните от животните продукти са много по-различни от диетата с високо съдържание на въглехидрати, която обикновено им се предлага в плен. Бърнестите мечки, които са местни за Индия, обикновено живеят само около 17 години в зоологически градини в САЩ, почти две десетилетия по-малко от максималната продължителност на живота, постижима при грижи за тях. Най-честата причина за смъртта им е рак на черния дроб.
Изследователите забелязват подобен модел и при предишни проучвания на полярни мечки. Те показват, че в плен тези животни обикновено се хранят с продукти с високо съдържание на протеини. Ако им се даде възможност на избор, те предпочитат богатата на мазнини диета, типична за дивите полярни мечки. Този вид животни в зоологическите градини обикновено умират около 10 години по-рано, най-често от бъбречно и чернодробно заболяване, които могат да се развият от дългосрочно възпаление на съответните органи, потенциален резултат от дългогодишна лошо балансирана диета, казват специалистите.